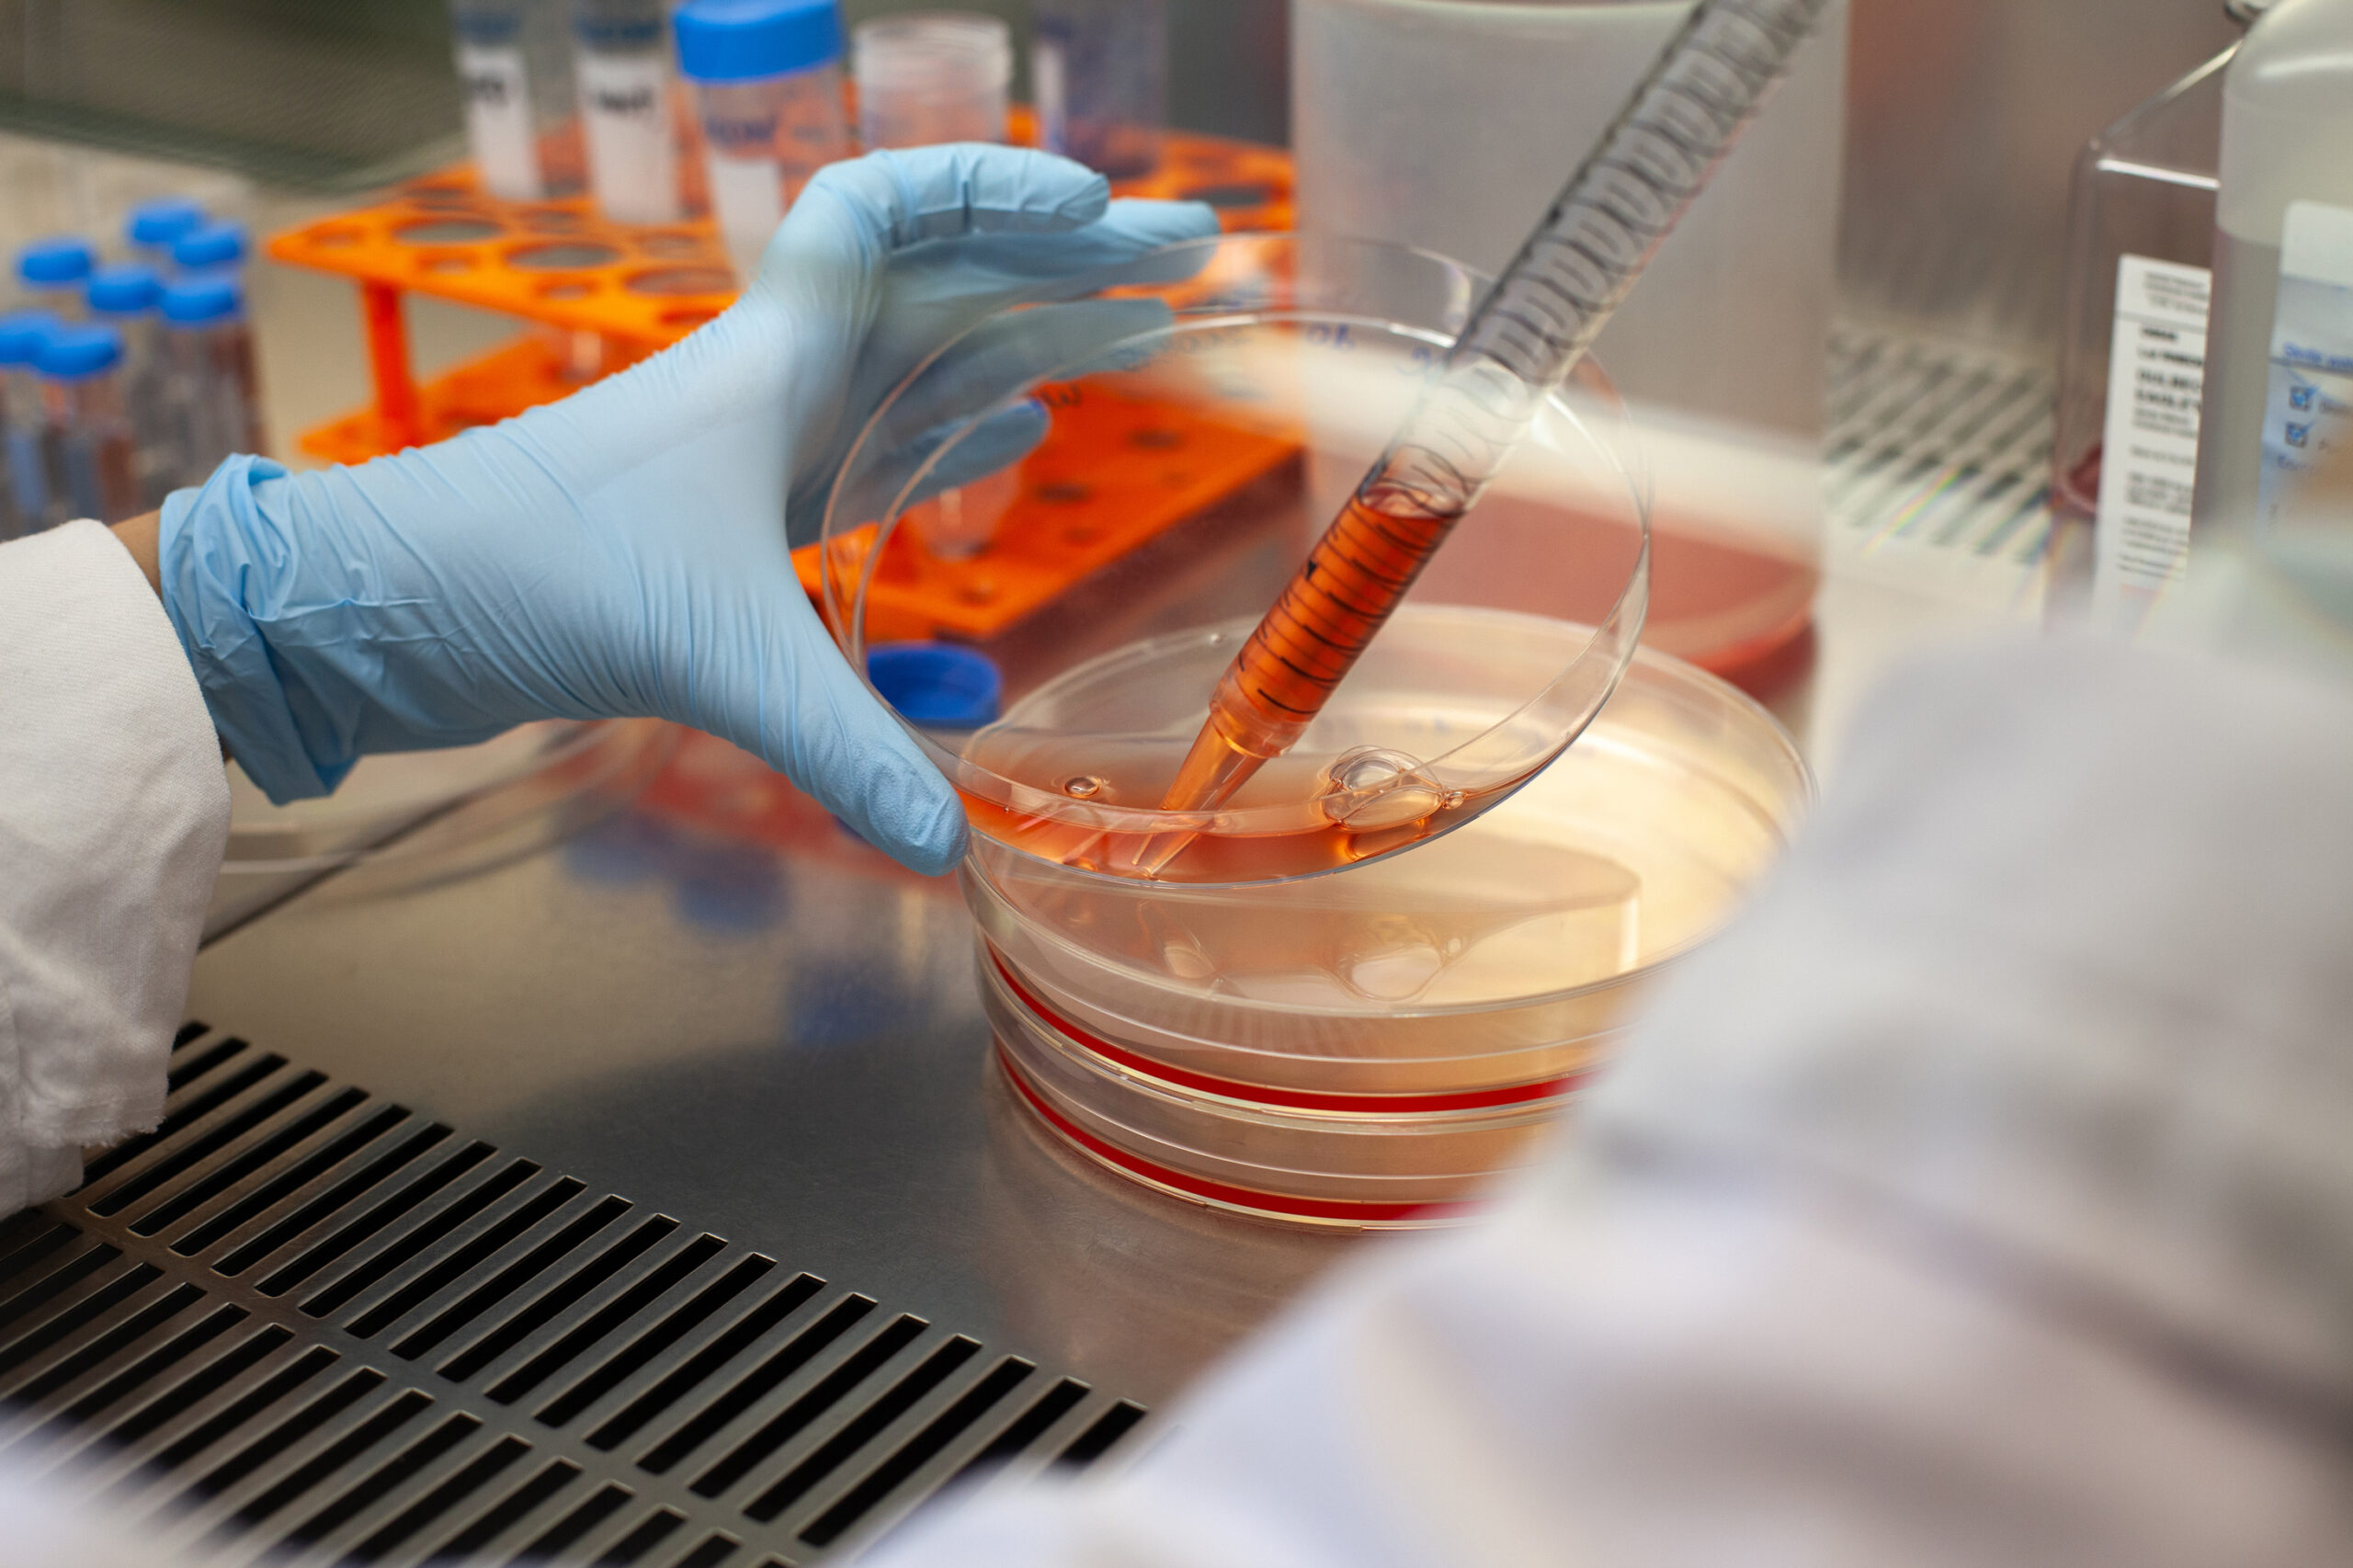

Boggo Road Innovation Junction (BRIJ) is committed to advancing human and planetary health through transformative technologies that accelerate scientific discovery and commercialisation.
Our interconnected community thrives on idea exchange, collaboration, and collective progress. It attracts the brightest talent from around Australia and the world to propel the next generation of breakthroughs in environmental sciences and healthcare.
A formidable concentration of expertise united to solve complex challenges
Our founding alliance brings together expertise from government departments, clinical therapeutics, translational research, environmental science, and digital healthcare. BRIJ draws strength from international expertise and Australian research excellence, guided by the enduring knowledge of Traditional Custodians.
BRIJ builds on Queensland’s proven formula for success – where bold ideas grow into ASX-listed companies and worldwide health solutions.
PRECINCT FOOTPRINT
280,000sqm
(includes PAH facilities)
~A$90bn
commercial sales derived from BRIJ innovations since 2006 to present
A$35m+
annual royalties from innovations at BRIJ
A$270m+
annual R&D investment currently flowing through organisations at BRIJ
A$400m+
funding raised by BRIJ startups from seed to growth stages (2021-2025)
100+
years of healthcare delivery & clinical innovation
~13k+
scientists, clinicians, support staff* & students on site^
200+
active clinical trials
719k+
patient services provided annually by Princess Alexandra Hospital
Built for accelerated results
From flexible workspace and communal areas for growing organisations to new walkways and underground rail links, we’re evolving a uniquely Queensland innovation ecosystem that attracts global talent and connects clinical research spaces, university collaboration hubs, advanced manufacturing facilities and Brisbane’s CBD in minutes. This is where Australia’s most promising startups find the infrastructure and partnerships they need to compete globally. Secure premium commercial space, back pioneering research, or partner with BRIJ’s industry-leading facilities and proven scalability.









